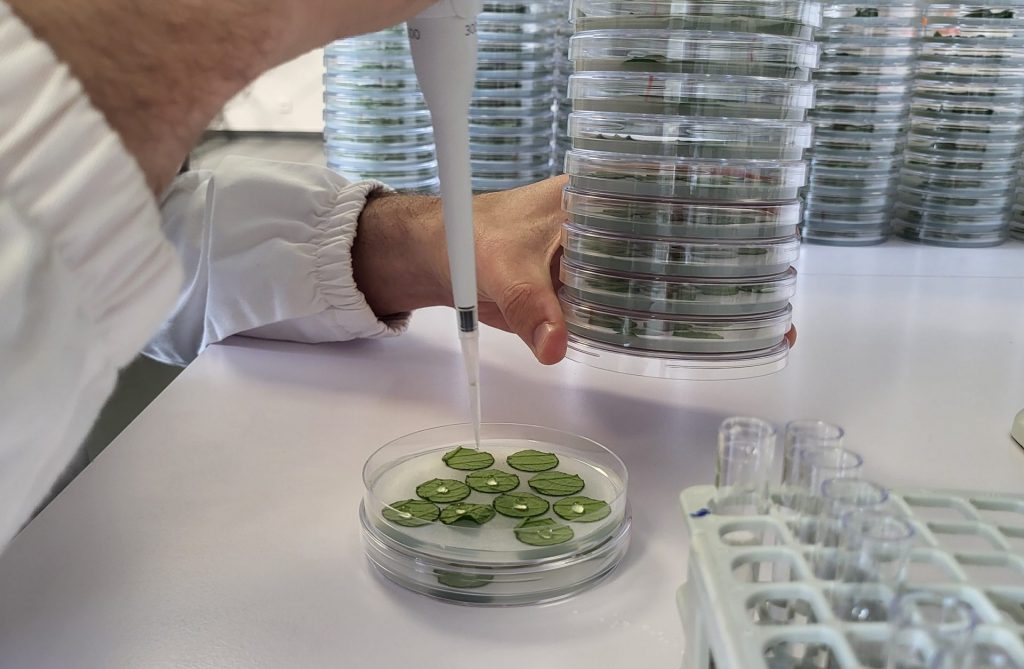
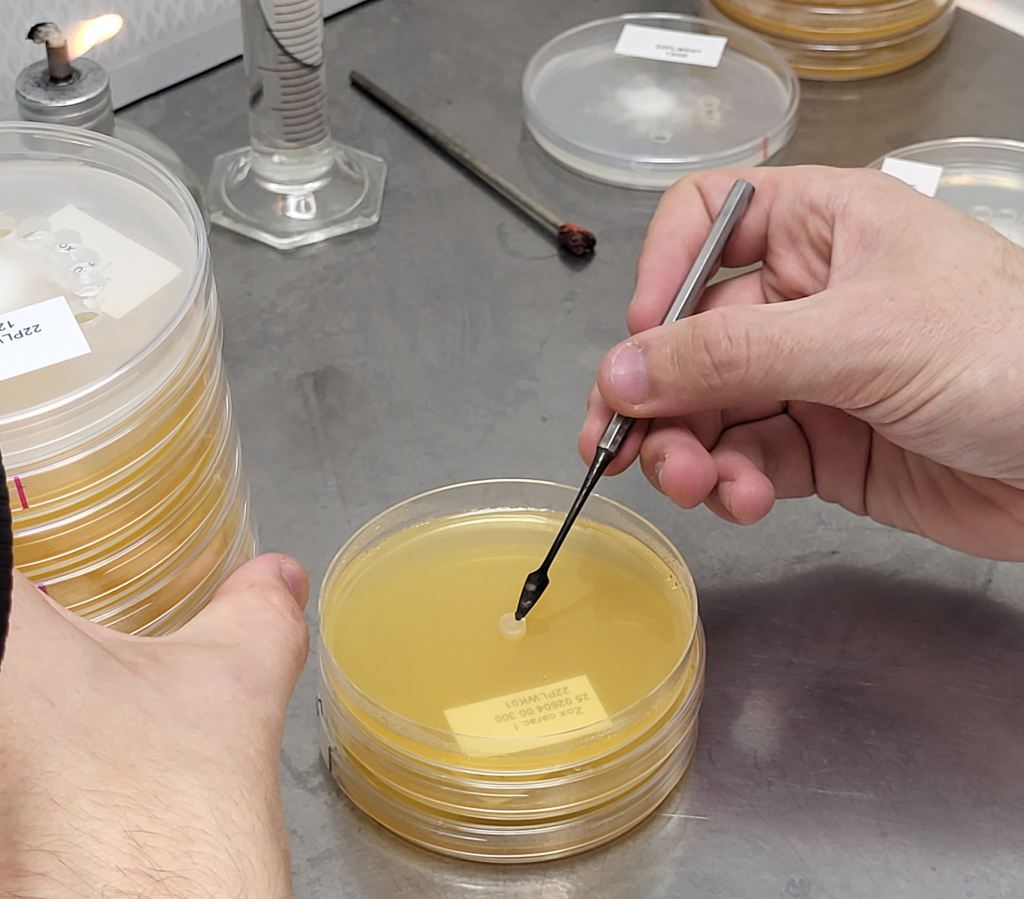
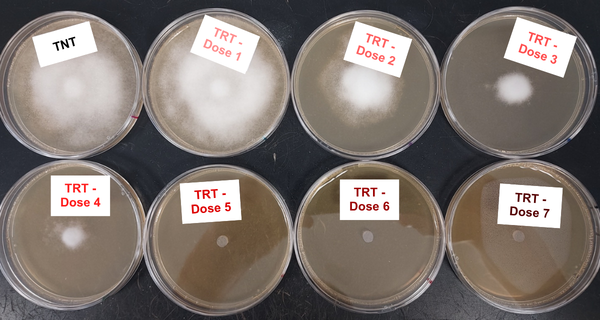

Resistance monitoring: Assessing pathogen sensitivity to active ingredients
For over 30 years, Staphyt’s Phytopathology and Plant Nutrition Laboratory has supported its clients in the selection, testing, and evaluation of active substances and formulated products, both prior to and following regulatory approval.
One of the laboratory’s core areas of expertise is the monitoring of crop pathogen sensitivity to various active ingredients.

1.DETECTION OF RESISTANCE
Fungicide resistance
The management of fungal diseases in crops relies on a combination of strategies, including the application of plant protection products. However, under certain conditions, phytopathogenic fungi can develop resistance to these treatments.
To limit the emergence of resistance and maintain the long-term effectiveness of fungicides in the field, it is crucial to monitor the sensitivity of pathogens to various active substances. Based on these observations, tailored recommendations are provided to support preventive measures and implement effective resistance management strategies, thereby ensuring sustainable crop protection.
With over 30 years of expertise, Staphyt has developed robust monitoring approaches traditionally based on in vivo and in vitro assays. These methods are now complemented by molecular biology tools, which allow the detection, identification, and quantification of resistance-associated mutations.
The laboratory evaluates the sensitivity of a wide range of pathogens-including Plasmopara viticola and Erysiphe necator (grapevine downy and powdery mildew), Sclerotinia, Botrytis cinerea (grey mold), Phytophthora infestans (potato late blight), Monilia (brown rot), Septoria tritici (wheat leaf blotch), Bremia lactucae (lettuce downy mildew)-to various active ingredients such as CAA, QoI, SDHI, QiI, OSBPI, benzamides and many others. Additional pathogens can also be assessed upon request.




In vivo testing

In vitro testing
2.WHY CHOOSE STAPHYT
Extensive sampling capabilities
The first step of monitoring involves collecting samples from the field. Samples consist of infected plant material (e.g., grapevine leaves showing mildew symptoms) collected randomly and in sufficient numbers to represent the pathogen population within a given area/country.
Staphyt relies on a wide network of stations and historical partners, supported by trained technical teams for sample collection. This enables clients to benefit from analyses conducted on samples from across Europe, providing an accurate overview of pathogen sensitivity.

Proven expertise
With over three decades of experience, the laboratory specializes in monitoring pathogen sensitivity, from establishing baseline sensitivity to conducting annual monitoring. It has played a key role in developing monitoring methodologies and has in-depth knowledge of resistance mechanisms.
The team is composed of highly skilled technicians, each specializing in a specific pathosystem, ensuring reliable results delivered within expected timelines.
Genetic confirmation
When resistance to an active ingredient is genetically characterized, molecular tools allow for the direct detection of specific mutations responsible for this resistance in the pathogen’s genome, as well as their quantification. In addition to conventional biological assays, the laboratory provides these advanced techniques to confirm and measure resistance levels.

Fast, consistent, and reliable results
The laboratory benefits from robust logistics to ensure full sample traceability. Upon receipt, samples are registered and coded according to strict quality procedures, before being integrated into monitoring programs.
Analyses are conducted daily to ensure rapid processing and to minimize subculturing, thereby preserving population compositions as close as possible to those observed in the field. As a result, the data generated accurately reflect the actual sensitivity of pathogen populations.
Standardized methods are used, with internal control strains included in each assay to ensure consistency and reliability. For certain active ingredients, any detection of reduced sensitivity is systematically confirmed through additional testing, including molecular approaches when relevant.
Results are regularly communicated to clients throughout the season, in the form of summary tables, with final reports delivered within agreed timelines.
Staphyt’s team provides continuous support at every stage of the monitoring program, from sample collection to data analysis, reporting, and presentation. In response to client needs, the laboratory also offers a range of advanced services, including resistant strain characterization, fitness studies, cross-resistance analysis, efficacy trials, compatibility assessments, and more.
For further information, please do not hesitate to contact us at: contact@staphyt.com





